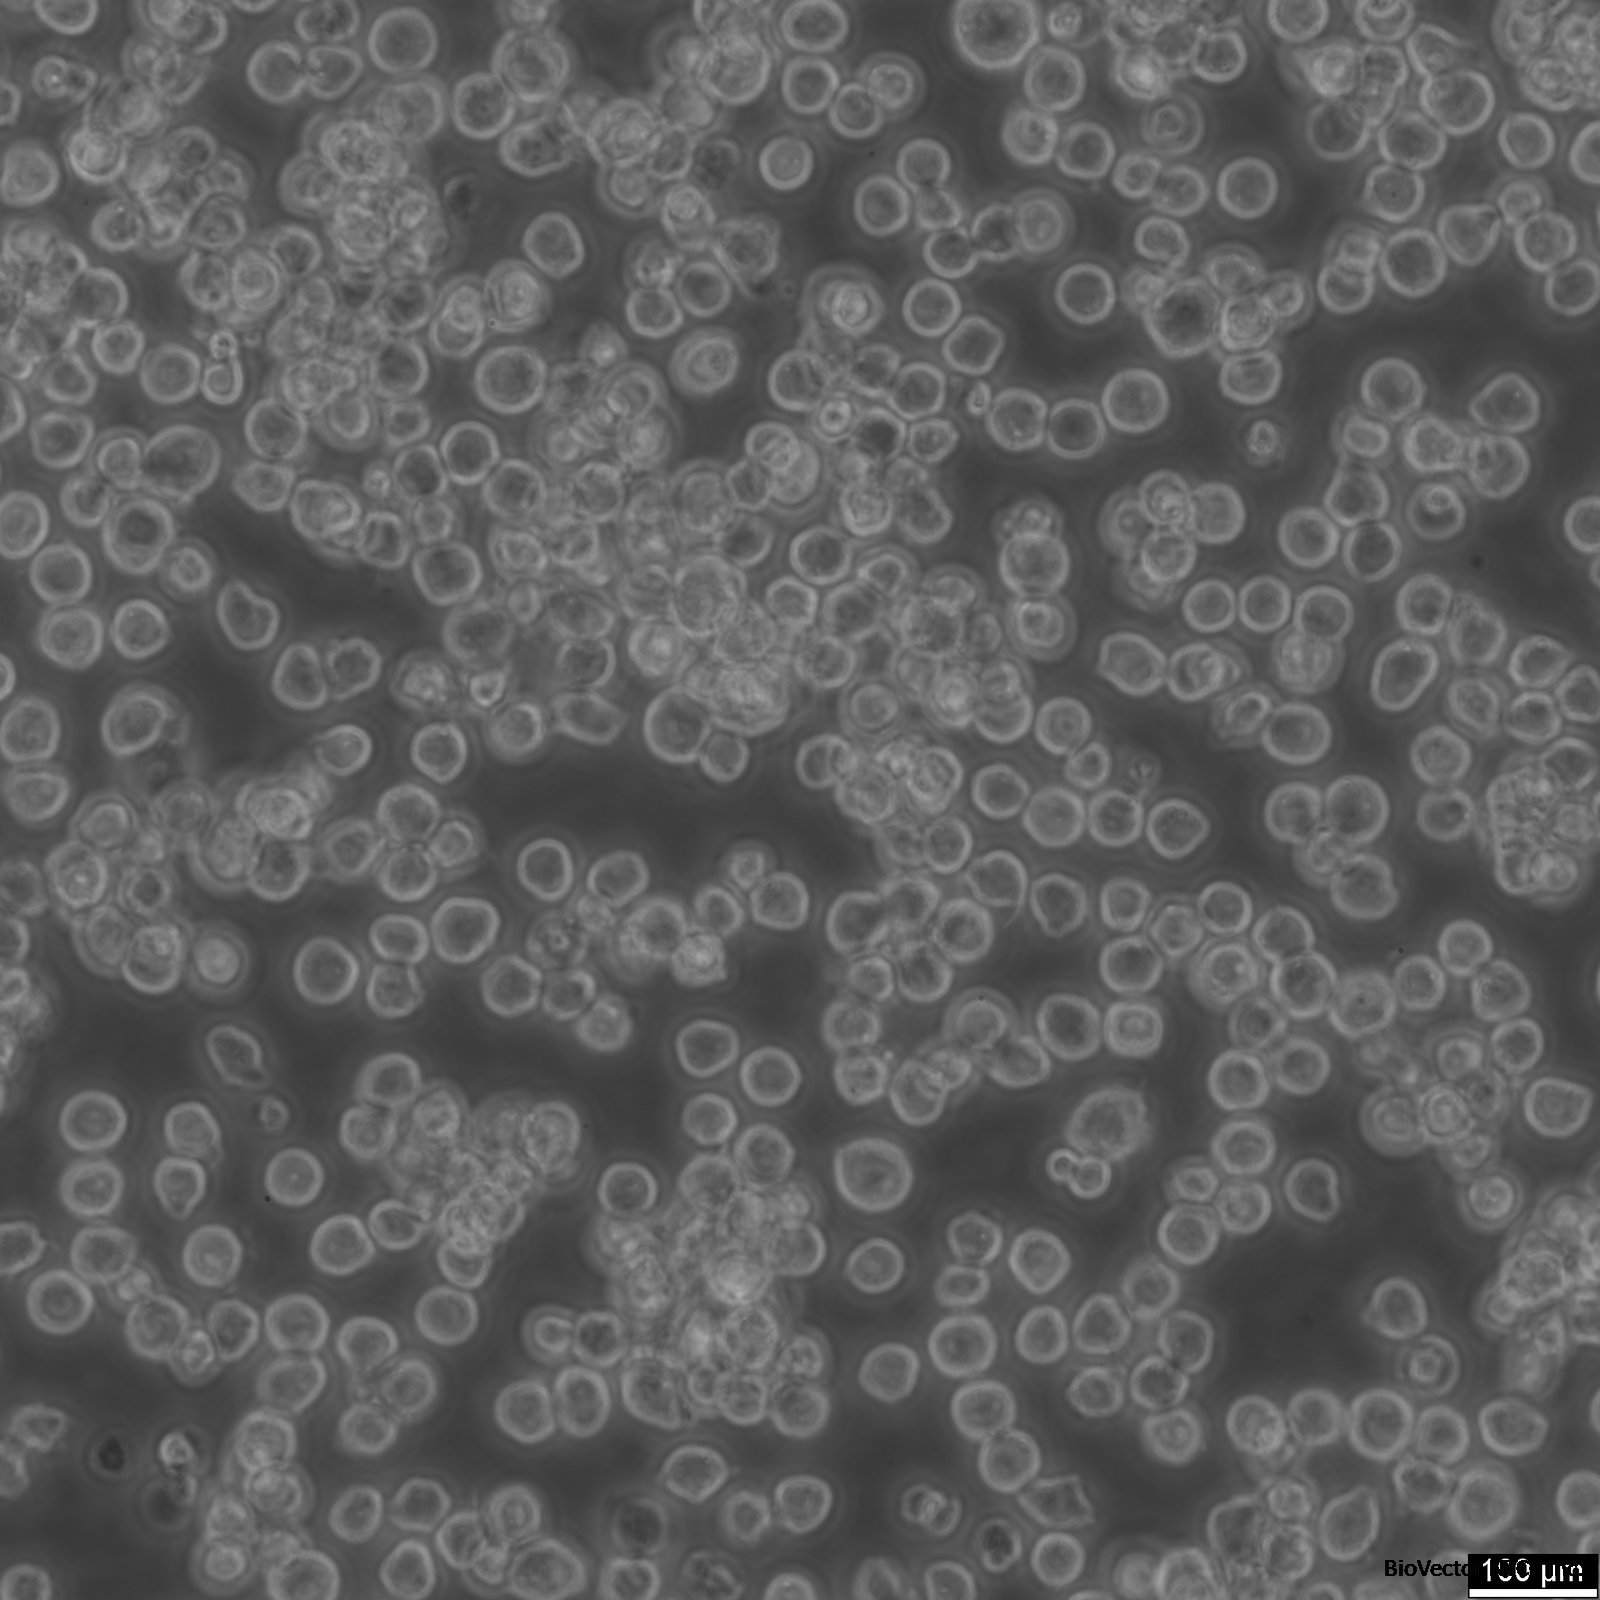
MH-S Cells

MH-S 小鼠肺泡巨噬细胞系 / BioVector® MH-S Mouse Alveolar Macrophage Cell Line
- 价 格:¥49950
- 货 号:BioVector® MH-S
- 产 地:北京
- BioVector NTCC典型培养物保藏中心
- 联系人:Dr.Xu, Biovector NTCC Inc.
电话:400-800-2947 工作微信:1843439339 (QQ同号)
邮件:Biovector@163.com
手机:18901268599
地址:北京
- 已注册
BioVector® MH-S 小鼠肺泡巨噬细胞系 / BioVector® MH-S Mouse Alveolar Macrophage Cell Line
通用定义 / General Definition:
BioVector® MH-S 是一种源自 BALB/c 小鼠的永生化肺泡巨噬细胞系。该细胞系通过 SV40 病毒转化建立,保留了肺泡巨噬细胞的关键生理特征。MH-S 细胞具有活跃的吞噬能力,能够产生细胞因子,并表达巨噬细胞特异性表面标志物。作为研究肺部免疫学、呼吸道感染、哮喘、肺纤维化以及环境颗粒物(如 PM2.5)毒理学的标准模型,MH-S 提供了比原代细胞更高的实验重现性和操作便捷性。
BioVector® MH-S is an immortalized alveolar macrophage cell line derived from BALB/c mice. Established via SV40 transformation, the cell line retains the essential physiological characteristics of primary alveolar macrophages. MH-S cells exhibit active phagocytic capacity, produce various cytokines, and express macrophage-specific surface markers. As a standard model for studying pulmonary immunology, respiratory infections, asthma, lung fibrosis, and the toxicology of environmental particulates (e.g., PM2.5), MH-S offers superior experimental reproducibility and ease of handling compared to primary cells.
BioVector® MH-S 技术说明书 (Technical Datasheet)
中文版说明书 (Chinese Datasheet)
1. 产品基本信息
产品名称: BioVector® MH-S 小鼠肺泡巨噬细胞
组织来源: 肺 (Lung/Alveoli)
生长特性: 贴壁生长(有时伴有少量悬浮细胞)
细胞形态: 巨噬细胞样,呈圆形或多角形,具有典型的伪足结构。
2. 培养条件
基础培养基: BioVector® RPMI-1640 培养基。
血清添加: 10% BioVector® 优质胎牛血清 (FBS)。
关键添加剂: 需添加 0.05 mM $\beta$-巯基乙醇 ($\beta$-mercaptoethanol) 以维持细胞活性。
培养环境: 37 摄氏度,5% $CO_2$。
传代比例: 1:2 至 1:4;建议使用细胞刮刀(Scraper)或轻微胰酶消化进行传代,避免过度消化损伤膜受体。
3. 细胞应用
呼吸道感染研究: 研究肺部病原体(如结核杆菌、流感病毒)与巨噬细胞的相互作用。
炎症反应: 评估 LPS 或其他刺激物诱导的促炎细胞因子(TNF-$\alpha$, IL-6)释放。
吞噬实验: 定量检测细胞对荧光标记细菌或环境尘埃颗粒的吞噬效率。
4. 注意事项
贴壁性: MH-S 细胞贴壁较牢固,但在生长过快或营养不足时可能出现部分脱落悬浮,这属于正常现象。
激活状态: 巨噬细胞对培养基中的内毒素非常敏感,BioVector® 建议使用极低内毒素含量的 FBS。
English Datasheet
1. General Product Information
Product Name: BioVector® MH-S Mouse Alveolar Macrophage Cell Line
Tissue Source: Lung (Alveoli)
Growth Properties: Adherent (occasionally with some cells in suspension)
Morphology: Macrophage-like; round or polygonal with characteristic pseudopodia.
2. Culture Conditions
Basal Medium: BioVector® RPMI-1640 Medium.
Serum Supplement: 10% BioVector® Fetal Bovine Serum (FBS).
Key Supplements: Supplemented with 0.05 mM $\beta$-mercaptoethanol to maintain cellular redox balance and viability.
Incubation: 37 degrees Celsius, 5% $CO_2$.
Subculturing: 1:2 to 1:4 ratio; use a cell scraper or gentle trypsinization. Avoid prolonged enzymatic treatment to preserve membrane-bound receptors.
3. Applications
Respiratory Infection Modeling: Investigating the interaction between pulmonary pathogens (e.g., M. tuberculosis, Influenza virus) and host immune cells.
Inflammatory Response: Measuring the release of pro-inflammatory cytokines (TNF-$\alpha$, IL-6) induced by LPS or other irritants.
Phagocytosis Assays: Quantifying the uptake efficiency of fluorescently labeled bacteria or environmental particulate matter.
4. Key Usage Notes
Adhesion Profile: Healthy MH-S cells form a stable monolayer, but partial detachment may occur during rapid proliferation or nutrient depletion.
Activation Sensitivity: Macrophages are highly reactive to endotoxins. BioVector® recommends the use of ultra-low endotoxin FBS and certified pyrogen-free plasticware to prevent baseline activation.
注意 / Note: BioVector® MH-S 应在生物安全二级 (BSL-2) 条件下操作。该细胞系是替代原代支气管肺泡灌洗 (BAL) 细胞的高效工具,非常适合高通量筛选实验。
BioVector® MH-S should be handled under Biosafety Level 2 (BSL-2). This cell line is a highly efficient alternative to primary Bronchoalveolar Lavage (BAL) cells and is particularly well-suited for high-throughput screening assays.

BioVector NTCC质粒载体菌株细胞蛋白抗体基因保藏中心
E-mail: BioVector@163.com
http://www.biovector.net
- 公告/新闻




